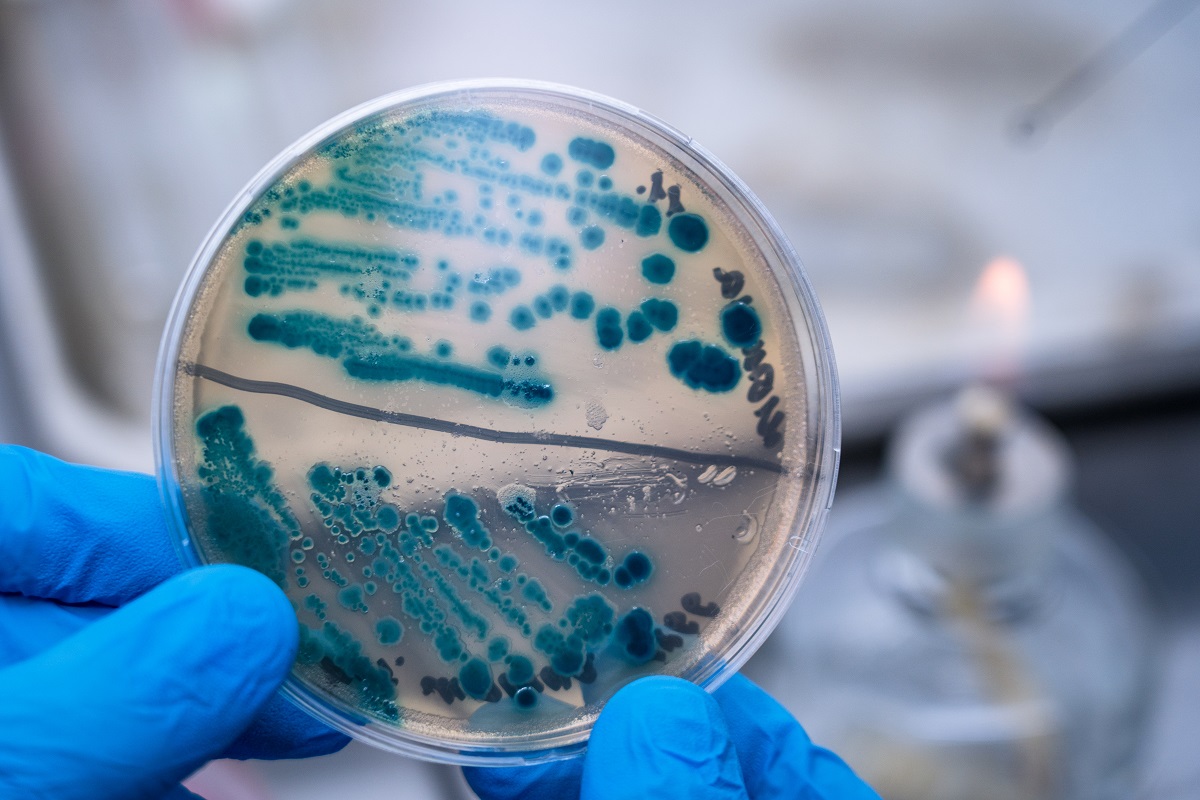

Россельхознадзор обсудил с ВОЗЖ аттестацию ФГБУ «ВНИИЗЖ» в качестве хранилища штаммов вируса чумы КРС
Аттестация Федерального центра охраны здоровья животных (ФГБУ «ВНИИЗЖ» Россельхознадзора) в качестве референт-лаборатории (хранилища) штаммов вируса чумы крупного рогатого скота обсуждалась на встрече заместителя руководителя Россельхознадзора Константина Савенкова с генеральным директором Всемирной организации здравоохранения животных (ВОЗЖ) Эммануэль Субейран и директором Департамента животноводства и охраны здоровья животных Продовольственной и сельскохозяйственной организации ООН (ФАО) Танаватом Тиенсином.
Начиная с 2011 года чума КРС считается искорененной во всем мире. ВОЗЖ и ФАО рекомендовали всем странам — членам организации уничтожить вирусосодержащие материалы (штаммы, антигены, вакцины и др.) либо обеспечить исключительно высокий уровень биобезопасности при их хранении.
«Именно такими условиями безопасного хранения в полной мере располагает ФГБУ «ВНИИЗЖ», — отмечается в сообщении ведомства.
«По итогам переговоров стороны договорились о подготовке и направлении пакета документов в сроки, установленные международной процедурой сертификации», — уточнили в Россельхознадзоре.
Встреча состоялась в Париже в рамках Генеральной ассамблеи делегатов ВОЗЖ, которая проходит с 25 по 29 мая.






Подписка на рассылку
Подпишитесь на нашу рассылку и будьте в курсе всех новостей
Нажимая на кнопку «Подписаться», Вы соглашаетесь на обработку персональных данных в соответствии с
«Политикой конфиденциальности»

















